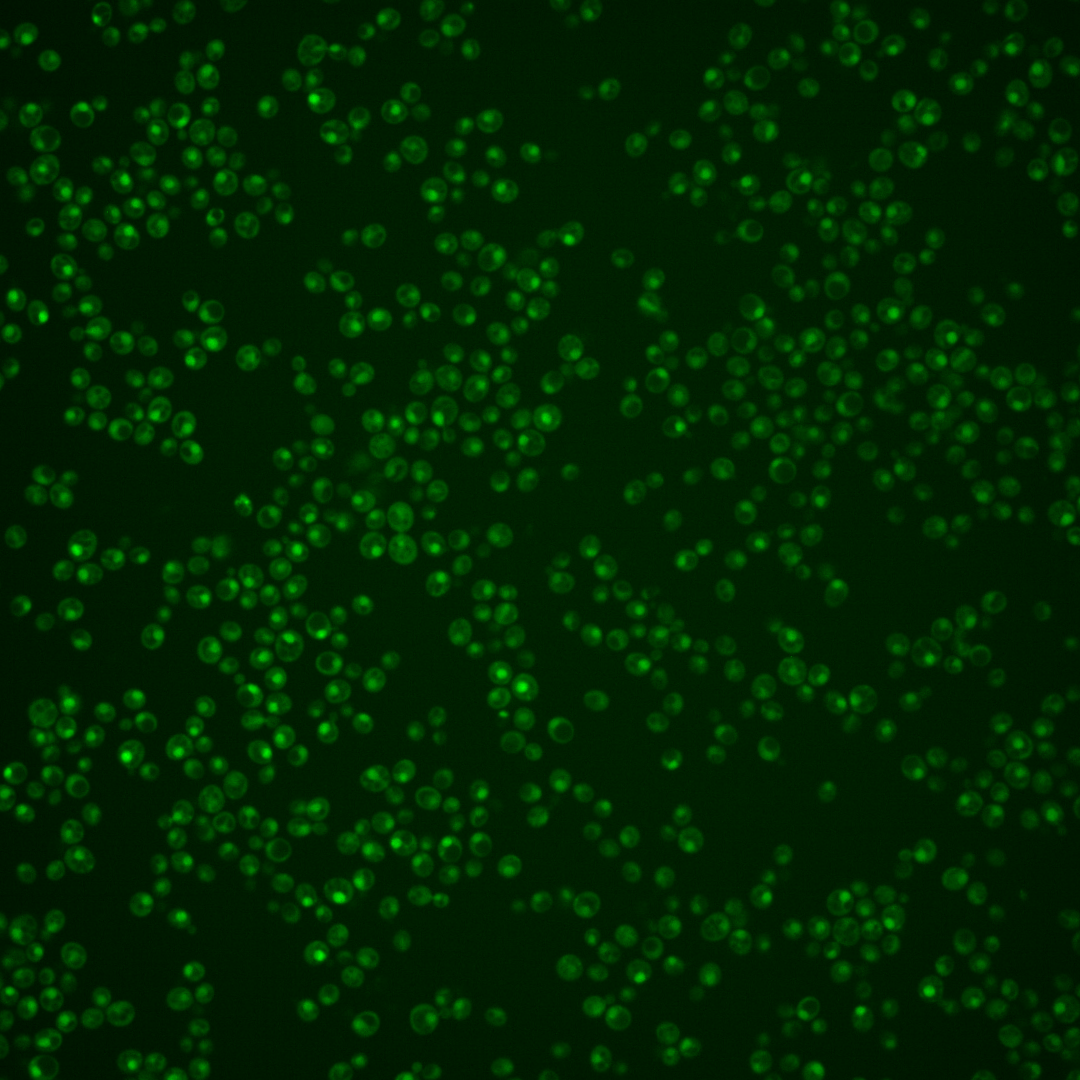

| Standard name | |
|---|---|
| Human Ortholog | |
| Description | Protein required for mismatch repair in mitosis and meiosis; forms a complex with Msh2p to repair both single-base & insertion-deletion mispairs; also involved in interstrand cross-link repair; potentially phosphorylated by Cdc28p |
Micrographs




















































































Sub-cellular Localization
Yeast GFP Assignment
Protein Abundance
Localization Change
External localization resources
| ensLOC | DeepLoc | |||||||||||||||||||||||
|---|---|---|---|---|---|---|---|---|---|---|---|---|---|---|---|---|---|---|---|---|---|---|---|---|
| Localization | WT1 | WT2 | WT3 | RAP60 | RAP140 | RAP220 | RAP300 | RAP380 | RAP460 | RAP540 | RAP620 | RAP700 | HU80 | HU120 | HU160 | rpd3Δ_1 | rpd3Δ_2 | rpd3Δ_3 | WT1 | WT2 | WT3 | AF100 | AF140 | AF180 |
| Cortical Patches | 0 | 0 | 0 | 0 | 0 | 0 | 0 | 0 | 0 | 0 | 0 | 0 | 0 | 0 | 0 | 0 | 0 | 0 | 0 | 0 | 0 | 0 | 0 | 0 |
| Bud | 0 | 0 | 1 | 0 | 0 | 3 | 2 | 3 | 8 | 4 | 5 | 3 | 0 | 0 | 0 | 0 | 0 | 0 | 2 | 2 | 3 | 1 | 4 | 2 |
| Bud Neck | 1 | 0 | 0 | 0 | 0 | 1 | 0 | 0 | 0 | 0 | 0 | 0 | 0 | 0 | 0 | 0 | 0 | 0 | 0 | 0 | 0 | 0 | 0 | 1 |
| Bud Site | 0 | 0 | 1 | 1 | 2 | 7 | 14 | 22 | 17 | 17 | 25 | 26 | 0 | 0 | 0 | 0 | 0 | 0 | – | – | – | – | – | – |
| Cell Periphery | 0 | 0 | 0 | 0 | 0 | 0 | 0 | 0 | 0 | 0 | 0 | 0 | 0 | 0 | 0 | 0 | 0 | 0 | 0 | 0 | 0 | 0 | 0 | 0 |
| Cytoplasm | 18 | 5 | 8 | 21 | 20 | 20 | 40 | 53 | 32 | 36 | 19 | 14 | 30 | 39 | 43 | 43 | 31 | 28 | 5 | 2 | 4 | 3 | 4 | 7 |
| Endoplasmic Reticulum | 0 | 0 | 0 | 0 | 0 | 0 | 0 | 1 | 1 | 0 | 0 | 0 | 0 | 0 | 1 | 7 | 7 | 3 | 0 | 0 | 0 | 0 | 0 | 0 |
| Endosome | 0 | 0 | 0 | 0 | 1 | 0 | 0 | 0 | 0 | 0 | 0 | 0 | 2 | 2 | 3 | 4 | 3 | 3 | 1 | 1 | 0 | 0 | 2 | 2 |
| Golgi | 0 | 0 | 0 | 0 | 0 | 0 | 0 | 0 | 0 | 0 | 0 | 0 | 0 | 0 | 0 | 2 | 1 | 2 | 1 | 0 | 0 | 0 | 0 | 0 |
| Mitochondria | 2 | 30 | 91 | 72 | 38 | 146 | 165 | 285 | 242 | 273 | 218 | 222 | 18 | 8 | 35 | 18 | 1 | 13 | 4 | 3 | 4 | 1 | 1 | 6 |
| Nucleus | 385 | 104 | 169 | 114 | 147 | 242 | 308 | 449 | 303 | 318 | 272 | 253 | 150 | 172 | 156 | 144 | 102 | 117 | 374 | 106 | 173 | 129 | 172 | 117 |
| Nuclear Periphery | 1 | 0 | 0 | 0 | 1 | 1 | 5 | 3 | 6 | 9 | 7 | 2 | 0 | 1 | 1 | 2 | 0 | 0 | 1 | 0 | 0 | 0 | 0 | 0 |
| Nucleolus | 0 | 1 | 0 | 1 | 1 | 6 | 9 | 30 | 23 | 28 | 29 | 35 | 3 | 4 | 1 | 2 | 2 | 3 | 0 | 0 | 0 | 1 | 2 | 6 |
| Peroxisomes | 0 | 0 | 0 | 0 | 0 | 0 | 0 | 0 | 0 | 0 | 0 | 0 | 0 | 0 | 1 | 0 | 0 | 0 | 0 | 0 | 0 | 0 | 0 | 0 |
| SpindlePole | 1 | 0 | 0 | 0 | 1 | 2 | 1 | 1 | 2 | 1 | 1 | 0 | 1 | 0 | 1 | 1 | 0 | 0 | 5 | 1 | 4 | 2 | 1 | 5 |
| Vac/Vac Membrane | 6 | 6 | 2 | 3 | 7 | 4 | 7 | 8 | 4 | 2 | 5 | 3 | 5 | 10 | 7 | 13 | 8 | 6 | 24 | 12 | 26 | 13 | 35 | 60 |
| Unique Cell Count | 409 | 121 | 209 | 154 | 187 | 313 | 402 | 588 | 413 | 438 | 370 | 340 | 197 | 225 | 226 | 207 | 147 | 162 | 425 | 132 | 221 | 157 | 230 | 214 |
| Labelled Cell Count | 414 | 146 | 272 | 212 | 218 | 432 | 551 | 855 | 638 | 688 | 581 | 558 | 209 | 236 | 249 | 236 | 155 | 175 | 425 | 132 | 221 | 157 | 230 | 214 |
Yeast GFP Assignment
Protein Abundance
| Screen | WT1 | WT2 | WT3 | RAP60 | RAP140 | RAP220 | RAP300 | RAP380 | RAP460 | RAP540 | RAP620 | RAP700 | HU80 | HU120 | HU160 | rpd3Δ_1 | rpd3Δ_2 | rpd3Δ_3 | AF100 | AF140 | AF180 |
|---|---|---|---|---|---|---|---|---|---|---|---|---|---|---|---|---|---|---|---|---|---|
| Mean Cell GFP Intensity (1e-4) | 6.0 | 4.3 | 3.9 | 4.2 | 4.8 | 4.2 | 4.3 | 4.2 | 3.7 | 3.7 | 3.6 | 3.5 | 5.4 | 5.4 | 4.7 | 8.7 | 9.7 | 9.2 | 5.1 | 5.1 | 5.6 |
| Std Deviation (1e-4) | 0.9 | 1.0 | 0.7 | 1.5 | 1.7 | 1.3 | 1.9 | 1.7 | 1.4 | 1.4 | 1.1 | 1.3 | 1.5 | 1.6 | 1.5 | 2.8 | 3.4 | 2.9 | 1.4 | 1.6 | 1.8 |
| Intensity Change (Log2) | – | – | – | 0.09 | 0.31 | 0.09 | 0.15 | 0.11 | -0.06 | -0.09 | -0.11 | -0.16 | 0.47 | 0.47 | 0.26 | 1.16 | 1.31 | 1.24 | 0.4 | 0.39 | 0.52 |
Localization Change
| Localization | RAP60 | RAP140 | RAP220 | RAP300 | RAP380 | RAP460 | RAP540 | RAP620 | RAP700 | HU80 | HU120 | HU160 | rpd3Δ_1 | rpd3Δ_2 | rpd3Δ_3 |
|---|---|---|---|---|---|---|---|---|---|---|---|---|---|---|---|
| Actin | – | – | – | – | – | – | – | – | – | – | – | – | – | – | – |
| Bud | – | – | – | – | – | – | – | – | – | – | – | – | 0 | – | – |
| Bud Neck | – | – | – | – | – | – | – | – | – | – | – | – | 0 | – | – |
| Bud Site | – | – | – | – | – | – | – | – | – | – | – | – | 0 | – | – |
| Cell Periphery | – | – | – | – | – | – | – | – | – | – | – | – | 0 | – | – |
| Cyto | – | – | – | – | – | – | – | – | – | – | – | – | – | – | – |
| Endoplasmic Reticulum | – | – | – | – | – | – | – | – | – | – | – | – | 0 | – | – |
| Endosome | – | – | – | – | – | – | – | – | – | – | – | – | 0 | – | – |
| Golgi | – | – | – | – | – | – | – | – | – | – | – | – | 0 | – | – |
| Mitochondria | – | – | – | – | – | – | – | – | – | – | – | – | 0 | – | – |
| Nuclear Periphery | – | – | – | – | – | – | – | – | – | – | – | – | 0 | – | – |
| Nuc | – | – | – | – | – | – | – | – | – | – | – | – | – | – | – |
| Nucleolus | – | – | – | – | – | – | – | – | – | – | – | – | 0 | – | – |
| Peroxisomes | – | – | – | – | – | – | – | – | – | – | – | – | 0 | – | – |
| SpindlePole | – | – | – | – | – | – | – | – | – | – | – | – | 0 | – | – |
| Vac | – | – | – | – | – | – | – | – | – | – | – | – | – | – | – |
| Cortical Patches | – | – | – | – | – | – | – | – | – | – | – | – | 0 | – | – |
| Cytoplasm | – | – | – | – | – | – | – | – | – | – | – | – | 0 | – | – |
| Nucleus | – | – | – | – | – | – | – | – | – | – | – | – | 0 | – | – |
| Vacuole | – | – | – | – | – | – | – | – | – | – | – | – | 2.9 | – | – |
External localization resources
Images






























Protein Concentration and Protein Localization Data
| R1 | R2 | R3 | ||||||||||||||||
|---|---|---|---|---|---|---|---|---|---|---|---|---|---|---|---|---|---|---|
| G1 Pre-START | G1 Post-START | S/G2 | Metaphase | Anaphase | Telophase | G1 Pre-START | G1 Post-START | S/G2 | Metaphase | Anaphase | Telophase | G1 Pre-START | G1 Post-START | S/G2 | Metaphase | Anaphase | Telophase | |
| Concentration | 2.0177 | 3.1357 | 3.1373 | 2.3169 | 2.5083 | 2.8544 | 2.8745 | 3.9868 | 3.9068 | 3.8214 | 3.655 | 3.1098 | 4.7086 | 5.3199 | 4.9437 | 4.9307 | 4.4148 | 4.2686 |
| Actin | 0 | 0 | 0 | 0.0001 | 0 | 0.0009 | 0.0142 | 0 | 0.0102 | 0.0011 | 0.0394 | 0.0037 | 0.0178 | 0 | 0 | 0.0022 | 0.0618 | 0 |
| Bud | 0 | 0 | 0.0001 | 0 | 0 | 0.0001 | 0.0003 | 0 | 0.0004 | 0.0001 | 0.0029 | 0 | 0.0006 | 0 | 0 | 0.0001 | 0.0001 | 0 |
| Bud Neck | 0.0001 | 0.0001 | 0.0002 | 0.0004 | 0.0011 | 0.0035 | 0.0012 | 0.0001 | 0.0006 | 0.0001 | 0.0136 | 0.0006 | 0.0017 | 0 | 0.0001 | 0.0002 | 0.0002 | 0.0006 |
| Bud Periphery | 0 | 0 | 0.0002 | 0 | 0 | 0.0001 | 0.0005 | 0 | 0.0007 | 0.0003 | 0.0046 | 0 | 0.0023 | 0 | 0 | 0.0002 | 0.0002 | 0 |
| Bud Site | 0 | 0 | 0.0006 | 0 | 0.0001 | 0.0001 | 0.0024 | 0 | 0.0025 | 0.0002 | 0.0112 | 0.0001 | 0.0048 | 0 | 0 | 0.0011 | 0.0001 | 0 |
| Cell Periphery | 0 | 0 | 0 | 0 | 0 | 0 | 0.0001 | 0 | 0.0001 | 0.0001 | 0.0007 | 0 | 0.0009 | 0 | 0 | 0.0001 | 0 | 0 |
| Cytoplasm | 0.0003 | 0.0009 | 0.0002 | 0.0012 | 0.0002 | 0.0006 | 0.0086 | 0.0004 | 0.0014 | 0.0003 | 0.0079 | 0.0001 | 0.0016 | 0 | 0.0223 | 0.0003 | 0 | 0 |
| Cytoplasmic Foci | 0 | 0 | 0 | 0.0001 | 0 | 0.0001 | 0.0145 | 0 | 0.0102 | 0.007 | 0.0468 | 0.0021 | 0.0245 | 0 | 0.0001 | 0.0095 | 0.0001 | 0 |
| Eisosomes | 0 | 0 | 0 | 0 | 0 | 0 | 0.0001 | 0 | 0.0001 | 0 | 0.0002 | 0 | 0.0003 | 0 | 0 | 0.0001 | 0 | 0 |
| Endoplasmic Reticulum | 0 | 0.0001 | 0 | 0.0001 | 0 | 0.0001 | 0.0032 | 0 | 0.0005 | 0.0014 | 0.0042 | 0.0001 | 0.0019 | 0 | 0.0001 | 0.0005 | 0 | 0 |
| Endosome | 0 | 0.0001 | 0 | 0.0003 | 0 | 0.0003 | 0.0096 | 0 | 0.0088 | 0.0429 | 0.0828 | 0.0013 | 0.0263 | 0 | 0 | 0.0269 | 0.0001 | 0 |
| Golgi | 0 | 0 | 0 | 0 | 0 | 0.0001 | 0.0046 | 0 | 0.0062 | 0.0174 | 0.0538 | 0.0016 | 0.0107 | 0 | 0 | 0.01 | 0.0001 | 0 |
| Lipid Particles | 0 | 0 | 0 | 0.0001 | 0 | 0 | 0.0078 | 0 | 0.0091 | 0.0095 | 0.035 | 0.0032 | 0.0546 | 0 | 0 | 0.0395 | 0.0003 | 0 |
| Mitochondria | 0.0001 | 0.0001 | 0.0001 | 0.0001 | 0.0001 | 0.0002 | 0.0033 | 0.0001 | 0.0081 | 0.0288 | 0.0143 | 0.0003 | 0.0461 | 0 | 0.0002 | 0.0363 | 0.001 | 0 |
| None | 0.0001 | 0.0001 | 0.0006 | 0.0014 | 0 | 0.0002 | 0.0025 | 0.0002 | 0.0034 | 0.0001 | 0.0046 | 0.0001 | 0.0031 | 0 | 0.0002 | 0.0004 | 0.0001 | 0 |
| Nuclear Periphery | 0.0012 | 0.0076 | 0.0011 | 0.0038 | 0.0005 | 0.002 | 0.0128 | 0.0012 | 0.0037 | 0.0012 | 0.0258 | 0.0007 | 0.0152 | 0.0001 | 0.001 | 0.0013 | 0.0047 | 0.0001 |
| Nucleolus | 0.0071 | 0.0091 | 0.0136 | 0.0059 | 0.0293 | 0.0222 | 0.0064 | 0.0074 | 0.007 | 0.0023 | 0.0061 | 0.0154 | 0.0137 | 0.0044 | 0.0044 | 0.0031 | 0.072 | 0.0174 |
| Nucleus | 0.9869 | 0.9783 | 0.9815 | 0.9788 | 0.968 | 0.9655 | 0.8854 | 0.9896 | 0.9054 | 0.8474 | 0.6122 | 0.9651 | 0.7141 | 0.9953 | 0.9713 | 0.8544 | 0.8571 | 0.9811 |
| Peroxisomes | 0 | 0 | 0 | 0 | 0 | 0 | 0.0144 | 0 | 0.0091 | 0.0326 | 0.0116 | 0.001 | 0.0304 | 0 | 0 | 0.0102 | 0.0004 | 0 |
| Punctate Nuclear | 0.0041 | 0.0033 | 0.0015 | 0.0075 | 0.0004 | 0.0038 | 0.006 | 0.0009 | 0.0099 | 0.0005 | 0.017 | 0.0045 | 0.0134 | 0 | 0.0001 | 0.0021 | 0.0006 | 0.0005 |
| Vacuole | 0 | 0.0001 | 0.0001 | 0.0001 | 0.0001 | 0.0001 | 0.0012 | 0.0001 | 0.0018 | 0.0031 | 0.0026 | 0.0001 | 0.0087 | 0 | 0.0001 | 0.0009 | 0.0003 | 0.0001 |
| Vacuole Periphery | 0 | 0.0001 | 0 | 0.0001 | 0 | 0 | 0.0009 | 0 | 0.001 | 0.0039 | 0.0025 | 0 | 0.0074 | 0 | 0.0001 | 0.0007 | 0.0009 | 0 |
Sequencing Data
| R1 | R2 | |||||||||
|---|---|---|---|---|---|---|---|---|---|---|
| G1 Post-START | S/G2 | Metaphase | Anaphase | Telophase | G1 Post-START | S/G2 | Metaphase | Anaphase | Telophase | |
| Gene Expression | 55.4809 | 15.3419 | 10.2066 | 22.3703 | 52.1757 | 43.473 | 12.1021 | 9.7476 | 15.0761 | 53.6127 |
| Translational Efficiency | 1.5152 | 1.3281 | 0.8227 | 0.9039 | 1.1317 | 1.8991 | 1.2455 | 0.7741 | 0.8429 | 0.9851 |
Hit Data
| Dataset | Hit |
|---|---|
| Protein Concentration | ✘ |
| Protein Localization | ✘ |
| Gene Expression | ✔ |
| Translational Efficiency | ✔ |
Endocytosis
| Temp | Actin Patch (Sac6-tdTomato) | Cortical Patch (Sla1-GFP) | Late Endosome (Snf7-GFP) | Vacuole (Vph1-GFP) |
|---|---|---|---|---|
| 37℃ | ||||
| RT |
Cell Cycle Omics
CYCLoPs (Msh6-GFP)
| Gene / Allele | Actin Patch (Sac6-tdTomato) | Cortical Patch (Sla1-GFP) | Late Endosome (Snf7-GFP) | Vacuole (Sac6-tdTomato) |
|---|
| Gene | Images |
|---|
| Gene | Images |
|---|
Images are not yet available
Images are not yet available